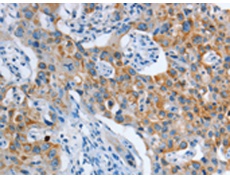
一抗

中文名稱:兔抗ASL多克隆抗體
|
Background: |
This gene encodes a member of the lyase 1 family. The encoded protein forms a cytosolic homotetramer and primarily catalyzes the reversible hydrolytic cleavage of argininosuccinate into arginine and fumarate, an essential step in the liver in detoxifying ammonia via the urea cycle. Mutations in this gene result in the autosomal recessive disorder argininosuccinic aciduria, or argininosuccinic acid lyase deficiency. A nontranscribed pseudogene is also located on the long arm of chromosome 22. Alternatively spliced transcript variants encoding different isoforms have been described. |
|
Applications: |
ELISA, IHC |
|
Name of antibody: |
ASL |
|
Immunogen: |
Fusion protein of human ASL |
|
Full name: |
argininosuccinate lyase |
|
Synonyms: |
ASAL |
|
SwissProt: |
P04424 |
|
ELISA Recommended dilution: |
2000-5000 |
|
IHC positive control: |
Human lung cancer and Human thyroid cancer |
|
IHC Recommend dilution: |
50-200 |

 購物車
購物車 幫助
幫助
 021-54845833/15800441009
021-54845833/15800441009